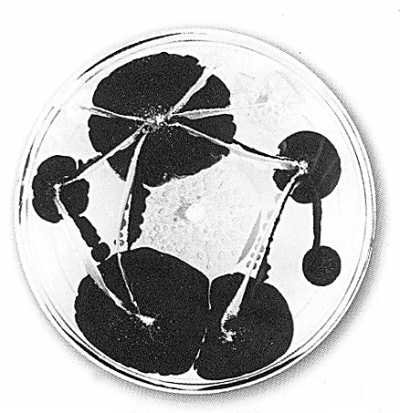

美国艺术家克拉丽·瑞思以科学的方式和工具进行绘画形式与内容的创新,其培养皿细胞型绘画作品因此获得广泛关注,被包括英国剑桥的微软研究所、美国斯坦福大学的医学中心以及中国上海的半岛酒店在内的世界各地的机构收藏和展出。在20几岁时瑞思被诊断出罹患克罗恩病,在做相关检查的过程中,她对血液与其他物质发生的化学反应产生了浓厚兴趣,这在后来成为她创作培养皿细胞型绘画的灵感之源。她将环氧基树脂加热着色后放在培养皿中,使其不断发生色彩和形状变化。
——摘自《文明》,2013年第7期

版权声明:凡《光明日报》上刊载作品(含标题),未经本报或本网授权不得转载、摘编、改编、篡改或以其它改变或违背作者原意的方式使用,授权转载的请注明来源“《光明日报》”。
| 报 纸 |  |
| 杂 志 |  |
|
| 《玄色电影里的雨伞》 [美]克拉丽·瑞思 |
美国艺术家克拉丽·瑞思以科学的方式和工具进行绘画形式与内容的创新,其培养皿细胞型绘画作品因此获得广泛关注,被包括英国剑桥的微软研究所、美国斯坦福大学的医学中心以及中国上海的半岛酒店在内的世界各地的机构收藏和展出。在20几岁时瑞思被诊断出罹患克罗恩病,在做相关检查的过程中,她对血液与其他物质发生的化学反应产生了浓厚兴趣,这在后来成为她创作培养皿细胞型绘画的灵感之源。她将环氧基树脂加热着色后放在培养皿中,使其不断发生色彩和形状变化。
——摘自《文明》,2013年第7期